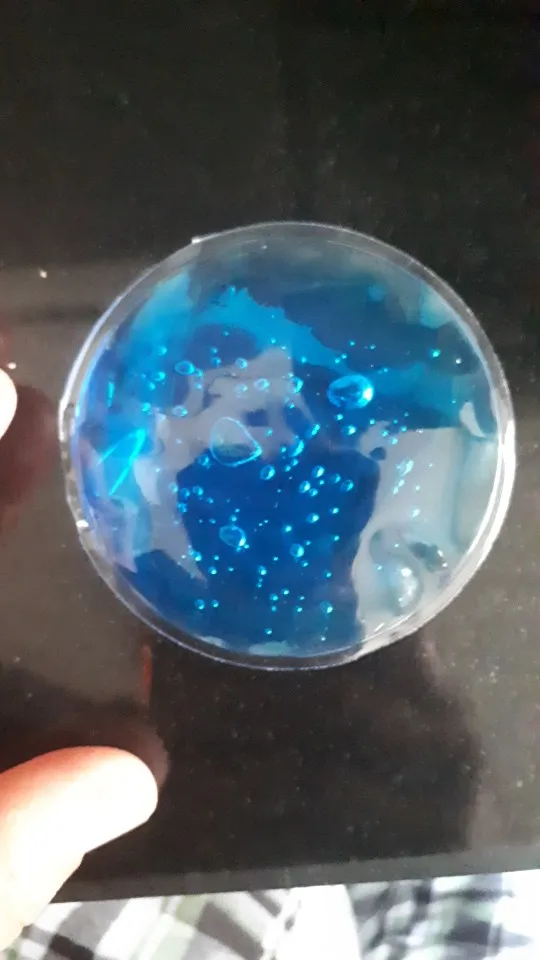
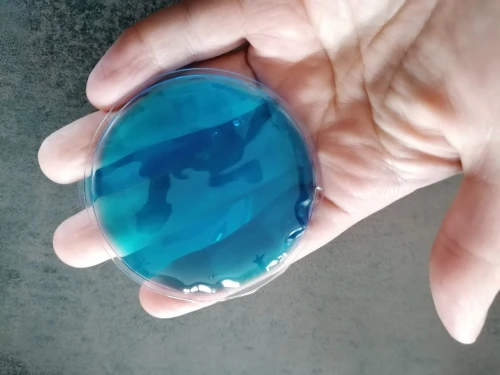
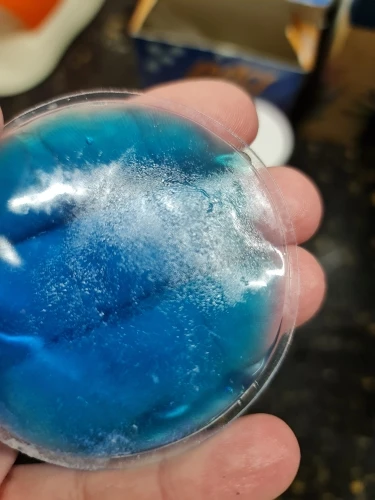

2020, 7 см, 1 шт, круглая форма, многоразовый, холодный лед, горячий гель, упаковка, терапия, без нагрева, облегчение боли, для холодной и горячей терапии, сумки 




Healthy everyday! Store - Надежность 89.75%
Более 2423 подписчиков, дата открытия магазина 09.01.2020
- Положительные оценки: 91% (1818)
- Соответствие описанию: 90%
- Отвечает на сообщения: 90%
- Скорость отправки: 88%
Последнее обновление: 15.09.2024
Отзывы покупателей
Страна: RU Доставка: Cainiao Saver Shipping For Special Goods 28.01.2021
Спасибо большое. Не знаю, как это будет в действии, но выглядит это неплохо. Спасибо продавцу. Пришло в конверте.
M***n
Страна: RU Доставка: Cainiao Super Economy for Special Goods 18.01.2021
Не увидела сначала что там 1 шт, думала пара, надо ещё одну теперь заказывать ( огорчило только это
N***a
Страна: RU Доставка: Cainiao Super Economy for Special Goods 03.03.2021
Замерзает, размерзает, все нормально.
A***a
Страна: RU Доставка: Cainiao Saver Shipping For Special Goods 24.02.2021
Все как на фото, в деле не пробовала
B***b
Страна: RU Доставка: Cainiao Super Economy for Special Goods 17.01.2021
Все хорошо
E***e
Страна: FR Доставка: Cainiao Super Economy for Special Goods 16.01.2021
Внимание, продается за единицу, а не за лот. Я был обманут imahes, которые позволяют себе предположить, что он продается партией
Z***z
Страна: CH Доставка: 4PX Singapore Post OM Pro 10.01.2021
Есть только 1 шт., означает, что он продается как пара, но не так. В противном случае все tiptop
J***o
Страна: FI Доставка: Cainiao Super Economy for Special Goods 07.03.2021
заказ не получила, деньги вернули
K***k
Страна: PL Доставка: Cainiao Super Economy for Special Goods 25.01.2021
nie dotarło. szybki zwrot kasy.........................................................................................................................................................................
A***n
Страна: PL Доставка: Cainiao Super Economy for Special Goods 22.12.2020
Хорошо. Только эти неприятные наклейки, а затем долго делает czysziccz растворителем
K***a
Страна: LV Доставка: Cainiao Super Economy for Special Goods 13.11.2020
Быстрая доставка в Ригу. Хорошие.
P***b
Страна: PL Доставка: Cainiao Super Economy for Special Goods 06.03.2021
Это одна штука.
I***a
Страна: CZ Доставка: Cainiao Super Economy for Special Goods 02.01.2021
Как и многие другие здесь, я верил, что изображение показывает две части и, безусловно, не прочитать Описание должным образом. Мне не кажется, что это может быть только одна штука. Так что я разочарован, но я думаю, что это была моя ошибка, даже с запутанной картиной...
K***d
Страна: FR Доставка: Cainiao Super Economy for Special Goods 12.01.2021
l article est arrivé endommagé mais j'ai été remboursée
V***z
Страна: HU Доставка: Cainiao Super Economy for Special Goods 26.10.2020
Хорошо
Покупатель
Страна: US Доставка: Cainiao Super Economy for Special Goods 22.12.2020
Спасибо!
A***s
Страна: IT Доставка: Cainiao Super Economy for Special Goods 22.11.2020
Товар соответствует описанию, только я был для глаз и вместо этого только дискета
Покупатель
Страна: RU Доставка: Cainiao Super Economy for Special Goods 22.01.2021
Очень расстроен, я думал, что приду 2 штуки, но я пришел 1
F***a
Страна: IT Доставка: Cainiao Super Economy for Special Goods 10.02.2021
Я прибыл все сломано с продуктом.
K***a
Страна: DE Доставка: Cainiao Super Economy for Special Goods 03.02.2021
К сожалению, это не видно, мужская пара kriegt No 1, Солнцезащитная только 1 накладка (не радует, позволяет чувствовать себя умышенно за светодиодной лампой! Доставка также длится дольше нескольких заказов
Покупатель
Страна: PL Доставка: Cainiao Super Economy for Special Goods 07.02.2021
Отгрузка, не dotarloo, обратный кассовый аппарат
M***h
Страна: RU Доставка: Cainiao Super Economy for Special Goods 09.03.2021
В комплект входит только одна штука. Почему они продают только один? Какой тип аферы это? Есть ли у людей только один глаз или что-то еще? Это было бы хорошо для пирата, возможно, но действительно плохо объяснено с укороченным уведомлением 1 шт. Что еще хуже, так это то, что Доставка занимает 2 месяца и 1 неделю. Разочарован. Не рекомендуется: (
H***h
Страна: IL Доставка: Cainiao Super Economy for Special Goods 23.02.2021
Только одна штука
Покупатель
Страна: US Доставка: Cainiao Super Economy for Special Goods 10.12.2020
Я не получил
G***r
Страна: RU Доставка: Cainiao Super Economy for Special Goods 10.02.2021
не пришло спустя несколько месяцев
C***e
Страна: FR Доставка: Cainiao Super Economy for Special Goods 14.03.2021
déçu car mal scellé le produit fuit...
Покупатель
Страна: UK Доставка: Cainiao Super Economy for Special Goods 08.03.2021
В нем было отверстие, и он протекал в упаковке
Покупатель
Страна: PT Доставка: 4PX Singapore Post OM Pro 07.03.2021
Не нравится продукт и думаю, что это две штуки!
K***a
Страна: UA Доставка: Cainiao Super Economy for Special Goods 15.02.2021
Заказ так и не получила, деньги никто не вернул. Благо что товар дешевый)
A***k
Страна: PL Доставка: Cainiao Super Economy for Special Goods 30.01.2021
Не получила товар. Срок ожидания закончился, спустя 3 месяца и я открыла спор. Доставка была платная, при чем сама доставка стоила дороже, чем сам заказ. Продавец не хотел возвращать деньги, хотел чтоб я дальше ждала. Но ждать не было ни малейшего желания. В спор вмешался Али и спор закрыли в мою пользу.
P***f
Страна: PL Доставка: Cainiao Super Economy for Special Goods 30.01.2021
Не otrzymalam. Заказ, но расстояние наличные
V***o
Страна: MX Доставка: Cainiao Super Economy for Special Goods 22.02.2021
Я не получил его у себя дома
K***a
Страна: PL Доставка: Cainiao Super Economy for Special Goods 01.02.2021
I don’t get it
A***a
Страна: PE Доставка: Cainiao Super Economy for Special Goods 14.12.2020
Я доверял изображению, а не описанию, в комплект входит только 1 штука
D***d
Страна: SK Доставка: Cainiao Super Economy for Special Goods 13.01.2021
Отличный
Покупатель
Страна: US Доставка: Cainiao Super Economy for Special Goods 29.12.2020
Я не получил